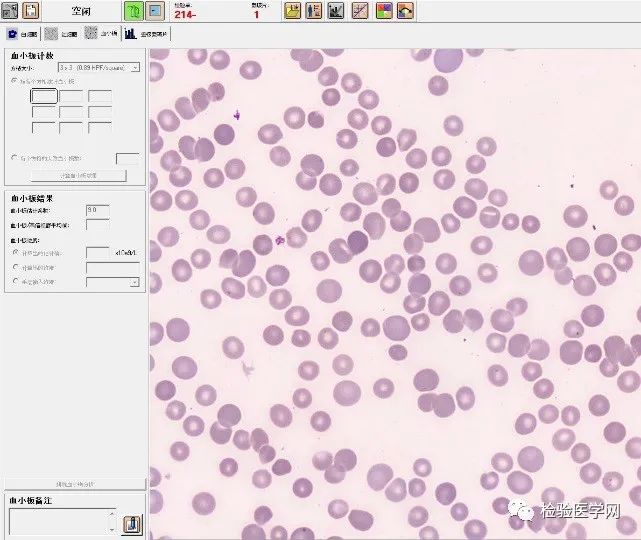

发现噬血细胞综合征?这要从那天的血小板复查中说起
原创 曾令军等 检验医学网
作者:曾令军 王保龙 邓芳 丁邦盛
单位:中国科技大学附属第一医院
导语
近期通过复查血小板发现一例疑似噬血细胞综合征(hemophagocytic syndrome, HPS),又称噬血细胞淋巴组织细胞增生症(hemophagocytic lymphohistocytosis, HLH)的患者,通过和临床沟通,增进对疾病了解,这是一个很好的案例,现报道如下。



如果仅仅观察血小板数据,的确让人困惑:激光发的结果与阻抗法的结果相差近4倍,并且仪器自动选择了激光法的检测结果,111×109/L。我仔细查看了直方图和散点图,发现血小板直方图存在明显的异常,尾部明显上翘,说明存在高端干扰,且PLT-O通道散点图存在明显异常,血小板的散点图与y轴交汇处,多出一个明显的异常区域,这种血小板散点图的异常是平时不多见的。因此,建议同事制作血涂片,染色镜检后,再确定血小板的真值。
由于惦记着这个病例,下午提前上班找到上午的标本,发现经过两个多小时的静置后,血浆外观浑浊,如下图3。

找到同事上午制作的血涂图片,在DI60上阅片,油镜视野下红细胞如图4:每个油镜视野血小板平均2~3个,据此粗略推算血小板数大约25~38×109/L,与同事报告35×109/L基本吻合。
至此,复查血小板结束,已经完美收官。但是异常血小板的直方图、散点图和职业的敏感性提示我,标本的背后一定存在某种端倪。于是登录LIS工作站,详细查看该病人的基本信息和其它检验报告,如图5。

生化结果中,血脂明显升高,甘油三酯TG:6.89mmol/L,乳酸脱氢酶LDH:507IU/L,也中度升高,备注中明显标注标本乳糜状态。7月27日纤维蛋白原Fb:0g/L。

血细胞降低、血小板降低、脂血、高脂血、低纤维蛋白?患者是否是噬血细胞综合?对患者加做血清铁蛋白SF,其结果为:1359ng/ml,这进一步印证了我的判断:这很可能就是噬血细胞综合征患者。


于是,我迅速与临床医生取得联系,了解到该患者是一名2岁的儿童,曾患急性髓系白血病,进行干细胞移植3个月后,因发热入院,初步诊断为肺部感染。目前病人仍在发热,治疗效果不佳,因呼吸衰竭住进重征监护病房,佩戴呼吸机。经过了解,临床医生对患儿的血脂,近段时间一直处于显著升高的状态,感到十分困惑。
了解这些基本的情况后,我结合噬血细胞综合征2004版的诊断标准[1],满足以下所述的(一)或(二)中以下8条指标中5条时,任何一项即可诊断。
(一)符合HLH的分子学诊断,主要为引起HLH的几种基因突变(略);
(二)
①√发热:体温>38.5 ℃,持续>7 d;
②脾大;
③√血细胞减少(外周血2或3系):Hb<90g/L Plt<100×109/L;
④√高三酰甘油血征和(或)低纤维蛋白原血症:TG>3mmol/L或高于同年龄的3个标准差,Fb<1.5g/L或低于同年龄的3个标准差;
⑤√在骨髓、脾脏、肝脏或淋巴结里找到噬血细胞;
⑥√SF≥500μg/L;
⑦√NK细胞活性降低或缺如;
⑧可溶性IL-2受体(Scd25>2400U/ml)升高。
同医生进行探讨,鉴于,患儿发热大于7天,外周血2系血细胞减少,甘油三酯升高和低纤维蛋白原血症,血清铁蛋白:1359ng/ml,建议临床医生考虑,患儿可能继发噬血细胞综合征,请他们完善骨髓穿刺和Nk细胞活性检测,临床医生同意了我的建议,并完善了相关的检查。
三天后骨髓报告结果出来,没有发现异常。至此,患儿已经满足噬血细胞综合征诊断标准中的4条,期待的骨髓报告中却没有文字描述发现噬血细胞,这无疑是对我诊断方向的一个沉重打击。是我的诊断思路错啦?还是骨髓中根本没有噬血细胞?抑或有噬血细胞而没有发现?这种种疑问弄昏了我的头脑,但是患儿的血脂明显升高,血清铁蛋白显著升高,外周血两系显著减少,纤维蛋白原结果曾经为0,凭直觉,这些证据都指向噬血细胞综合征。
于是,我找到骨髓片,自己在镜下认真查找,功夫不负有心人,在骨髓片中找到两个可疑细胞,但经仔细确认均不是。鉴别要点:当骨髓细胞增生活跃/稍减低,需要看到典型的吞噬细胞(完整的细胞被吞噬,吞噬细胞本身清晰可辨)才能确认,下图第一幅未见吞噬细胞本身的细胞核,第二幅两点均未见;当骨髓增生极度减低,此时大量造血细胞被吞噬细胞,可能已经吞无可吞,那么骨髓中可见大量激活状态的组织细胞,造血细胞极度减少,甚至不可见,该患者不属于此类情况。


骨髓穿刺后送检的骨髓片一般有5-7张,那么在其它骨髓片中,是不是还能找到典型的细胞?立即染色仅剩的一张骨髓片,显微镜下寻找不到两分钟,又发现两个疑似噬血细胞,经过上述鉴别要点比对,这两个细胞只能确认为组织细胞,并不能确认嗜血细胞,前者属于正常的细胞代谢,日常工作中我们在骨髓增殖活跃的非恶性疾病中偶见。至此,我们和临床医生沟通了患者的所有检查情况,希望能够进一步排除HLH,临床医生也很困惑一个骨髓移植的患者为什么会出现疑似HLH的现象。




那么这个特殊的患者血脂异常我们还能用于诊断HLH吗?另外该患者铁蛋白增高,又是什么原因呢?文献[3,4]提示,有42.2%的儿童急性白血病移植后会出现铁蛋白>350ng/mL,其中一个影响因素就是原发病为急性髓细胞性白血病,还有一个是GVHD,该患者此次入院是因为肺炎呼衰,是否是由于GVHD引起的,需要进一步检查确认,然而目前已有证据,已经充分解释了患者疑似HLH的所有检测指标。当我们再一次和临床联系后,临床明确了下一步治疗方案,对此表示感谢,也希望我们协助进一步观测是否一些指标在脐血移植后有同样或差异的表现。
此案件启示:诊断标准的应用是灵活多变的,根据患者不同情况,诊断标准有时候也不再是标准。敢于质疑,小心求证。
噬血细胞综合征(hemophagocytic syndrome, HPS),又称噬血细胞淋巴组织细胞增生症(hemophagocytic lymphohistocytosis, HLH),是一类由原发或继发性免疫异常导致的过度炎症反应综合征。这种免疫调节异常主要由淋巴细胞、单核细胞和巨噬细胞系统异常激活、增殖,分泌大量炎性细胞因子而引起的一系列炎症反应。临床以持续发热、肝脾肿大、全血细胞减少、高甘油三酯、低纤维蛋白原、高血清铁蛋白,以及骨髓、肝、脾、淋巴结组织发现噬血现象为主要特征。
HPS由于触发因素不同,被分为“原发性”和“继发性”两大类。前者主要发生于儿童,大多有家族史,并伴有基因异常;而后者可发生于各个年龄阶段,以感染、肿瘤、自身免疫病引起居多。
HPS最常见的实验室特征为:外周血异常为血细胞减少,常为两系或是全血细胞减少。肝功能异常主要表现为血清转氨酶、胆红素、乳酸脱氢酶升高、白蛋白水平降低伴有血甘油三酯水平升高。凝血功能异常,表现为凝血时间延长,纤维蛋白原含量明显降低。血清铁蛋白显著升高,可作为疾病活动的标志。
案例启示
首先 要严格执行复检规则。在日常工作中,发现异常血常规结果标本,不要怕麻烦,要及时进行涂片镜检,不能仅仅依赖机器结果。本例标本在进行血常规的检测过程中,发现血小板的直方图和散点图异常,阻抗法和流式激光染色法,结果相差近4倍,后经过血小板的显微镜下复核,证实是激光法(PLT-O)结果错误,阻抗法(PLT-I)结果是正确的,这就颠覆了检验工作者多认为激光法计数结果可靠性高的认知。
再者 要对常见疾病有高度敏感性,并且要综合生化、免疫和临床病例,及时和医师沟通。在此案例中通过血常规中血小板数量减低,散点图、直方图异常的表面现象,主动调阅生化结果,查阅电子病历,发现血脂明显升高,纤维蛋白原显著降低的实验室特征,高度怀疑噬血细胞综合征,主动加做血清铁蛋白实验,印证推断,并主动和临床联系。
最后 主动参与临床诊疗,大胆给与临床下一步建议,并给出适合的分层诊断报告,体现了一个检验医师高度的专业价值和负责的态度。案例中主动结合《血细胞分析报告规范化指南》,针对本例血小板计数异常,给出了分层报告,在层次2中提示1个可能的诊断方向(噬血细胞综合征)[2],并在层次3中给出了进一步完善骨髓穿刺和Nk细胞活性检测的适当建议。在实际的血细胞分析过程中,充分落实了复检规则,并进一步深化了《血细胞分析报告规范化指南》在实际工作中的运用,得到的临床医生的充分肯定。
故和临床沟通中,发现异常主动求真,并大胆推断,和临床主动沟通,用专业知识为患者的健康保驾护航,检验科的价值就掌握在自己的手中。

[1] 噬血细胞综合征中国专家联盟 中华医学会儿科学分会血液学组. 噬血细胞综合征诊治中国专家共识[J].中华医学杂,2018,98(2):91-95 : .DOI:10.3760/cma.j.issn.0376 2491.2018.02.004
[2] 中华医学会检验医学分会血液学与体液学学组. 血细胞分析报告规范化指南[J] . 中华检验医学杂志, 2020,43(6):619-627.DOI:10.3760/cma.j.cn.114452 20200331 00343
原标题:《发现噬血细胞综合征?这要从那天的血小板复查中说起......》

